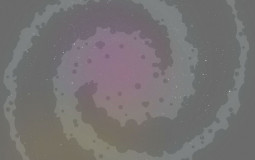
Istrolid Players

ALL TIER LIST TEMPLATES
Find the template you need and create your own tier ranking. You can then save your rank, download the image and share it.
CREATE YOUR TEMPLATE
Haven’t found the perfect template for your ranking? Quickly create your template by setting up the tiers and uploading the photos.